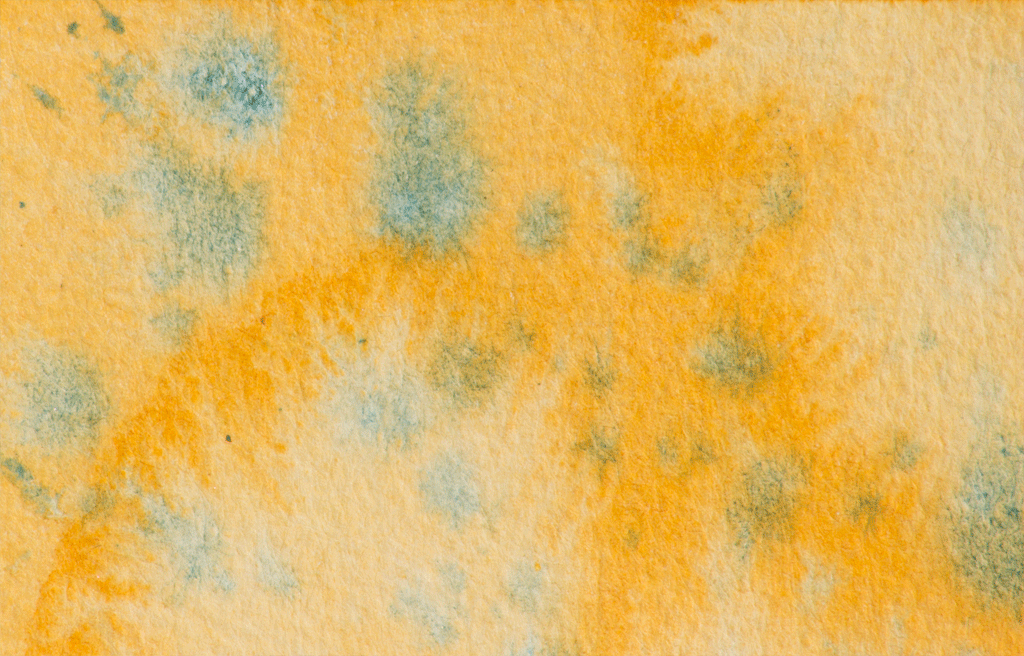

Free Delivery when you spend over £50*
*Free delivery within the UK (excluding the Channel Islands) when the order is over £50*
A J Ludlow Granulation and Disruptive Medium
Granulation and Disruption Medium is just one of the Watercolour Mediums to complement the A J Ludlow Professional Watercolour range. Made in the UK using the same fine quality materials we use to make our watercolours; this medium has been created to give an additional dimension and creativity to the artist.
This medium increases the granulation of the watercolour washes and can be used to disturb the surface of the watercolour in order to create interesting patterns and marks.
The medium works best when used on wet watercolour washes or when watercolour is introduced to the liquid medium on the paper. It causes the pigment to granulate and produce a mottled appearance. It can affect watercolours that normally have a smooth wash and can be used to create dramatic skies, leafy foliage, sandy beaches and gives extra versatility as not all pigments naturally granulate or are coarsely ground.
Detail from a watercolour painting by Carmen Renwick

When splattered onto wet watercolours, it causes star burst-like patterns (as shown in the top two photographs above}, whilst further interesting effects can be achieved using the medium as the wash water (as in the blue and green painting on the left-hand side of the bottom row) or wetting the paper with it first, before introducing watercolour (as in the red and yellow example).
An example of the effects created using the Granulation and Disruptive Medium: To create the effect shown below, drop neat granulation medium onto a wet wash of colour, which causes the yellow to reticulate. After allowing it to partially dry, feed the green into the areas where the medium had been dropped, to create the tendril-like clusters blossoming over the surface of the painting.
Details from an abstract painting using the A J Ludlow Granulation and Disruptive medium.
These notes are meant for guidance only and by no means, should have a limiting effect on the user’s inspiration or creativity. So how will you use this watercolour medium?